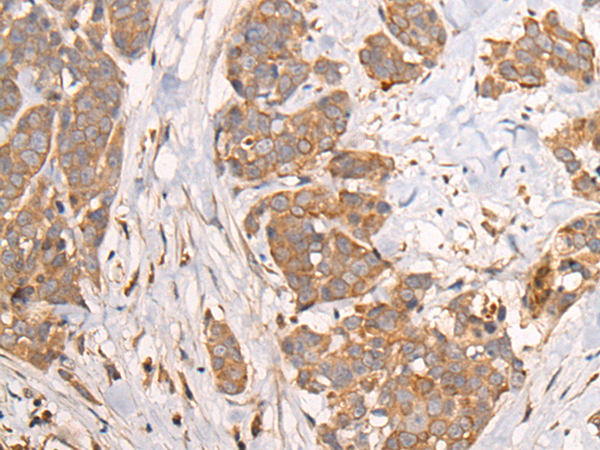
一抗

|
Background: |
The metallocarboxypeptidase family of enzymes is divided into 2 subfamilies based on sequence similarities. The pancreatic carboxypeptidase-like and the regulatory B-type carboxypeptidase subfamilies. Carboxypeptidase D has been identified as a regulatory B-type carboxypeptidase. CPD is a homolog of duck gp180, a hepatitis B virus-binding protein. Transcript variants utilizing alternative polyadenylation signals exist for this gene. |
|
Applications: |
ELISA, IHC |
|
Name of antibody: |
CPD |
|
Immunogen: |
Synthetic peptide of human CPD |
|
Full name: |
carboxypeptidase D |
|
Synonyms: |
GP180 |
|
SwissProt: |
O75976 |
|
ELISA Recommended dilution: |
5000-10000 |
|
IHC positive control: |
Human colorectal cancer and human thyroid cancer |
|
IHC Recommend dilution: |
25-100 |


 購物車
購物車 幫助
幫助
 021-54845833/15800441009
021-54845833/15800441009